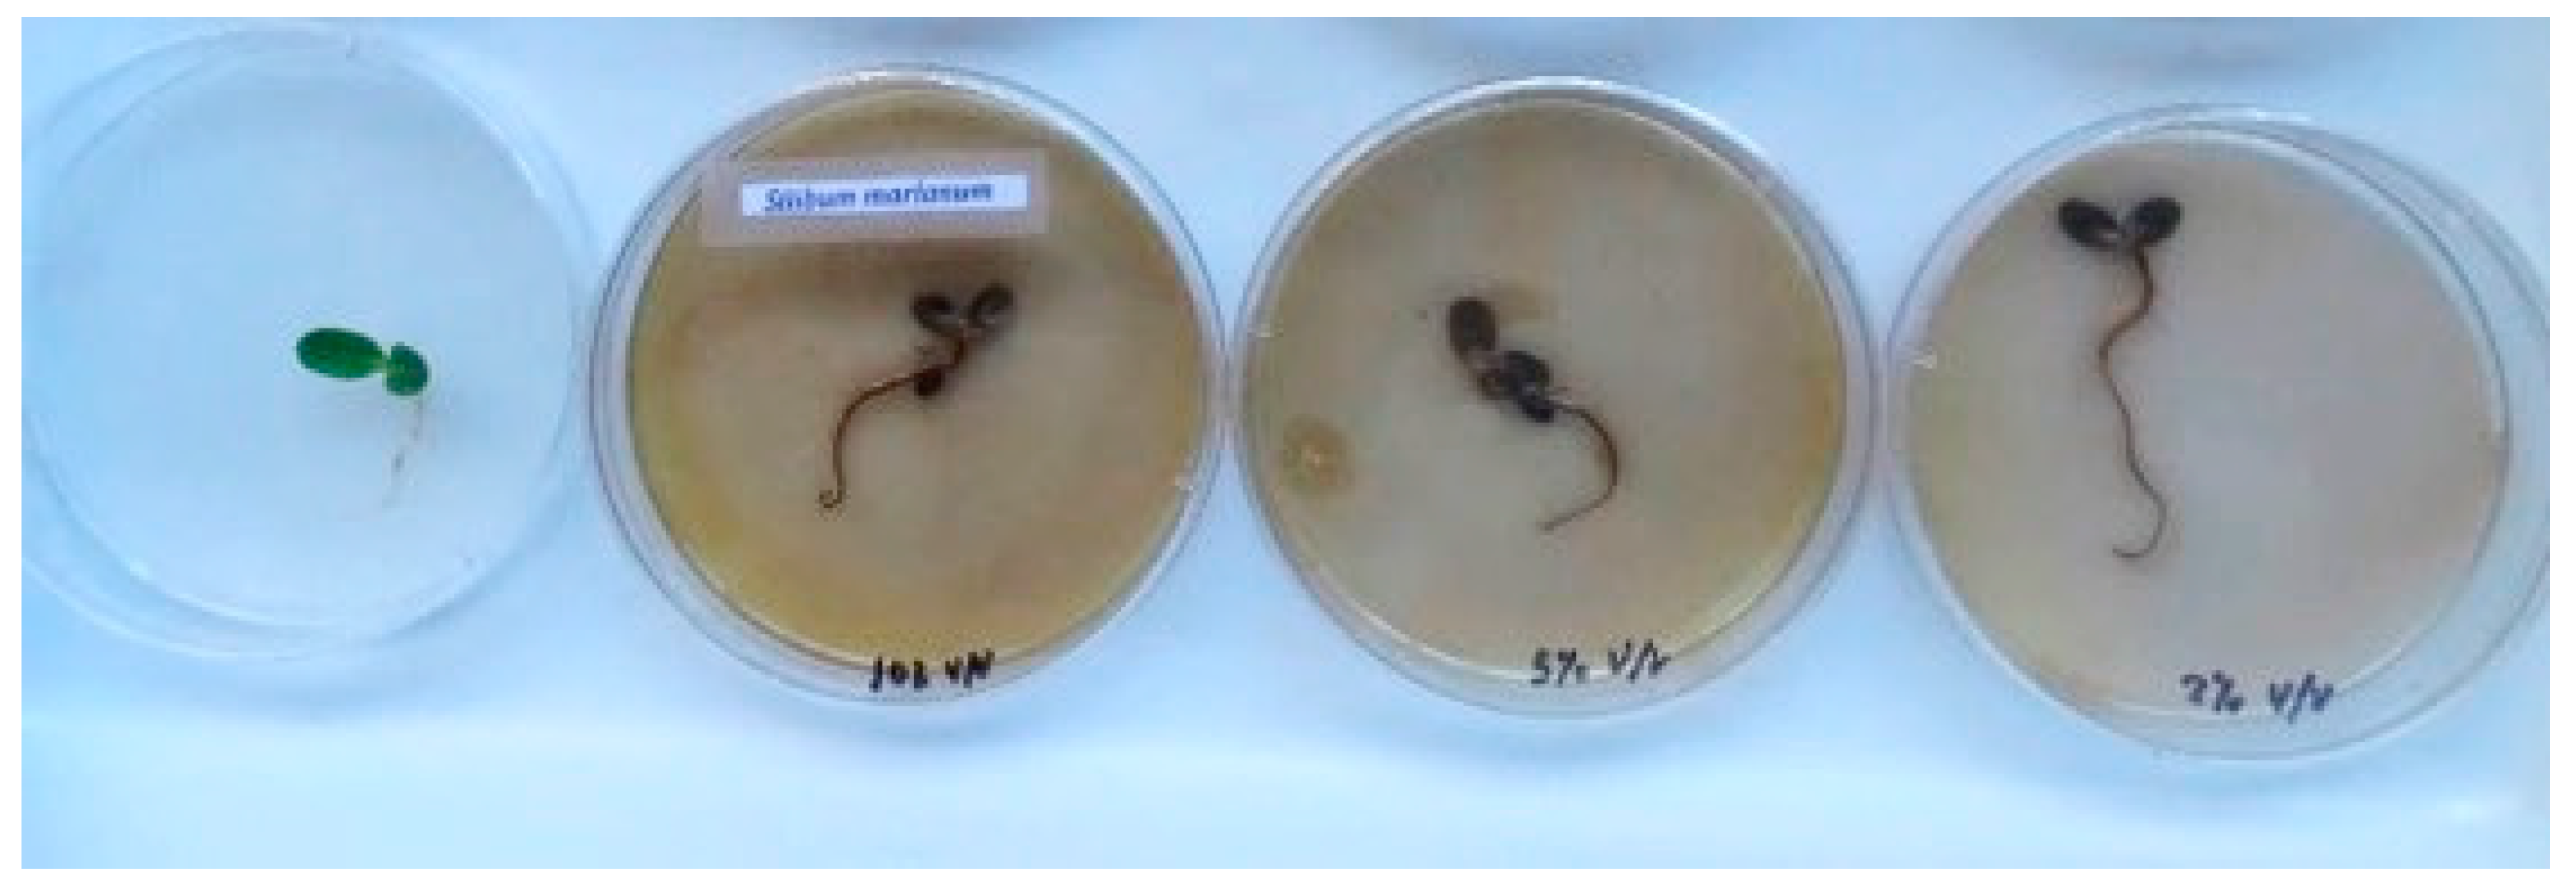
Energies 13 02418 g003
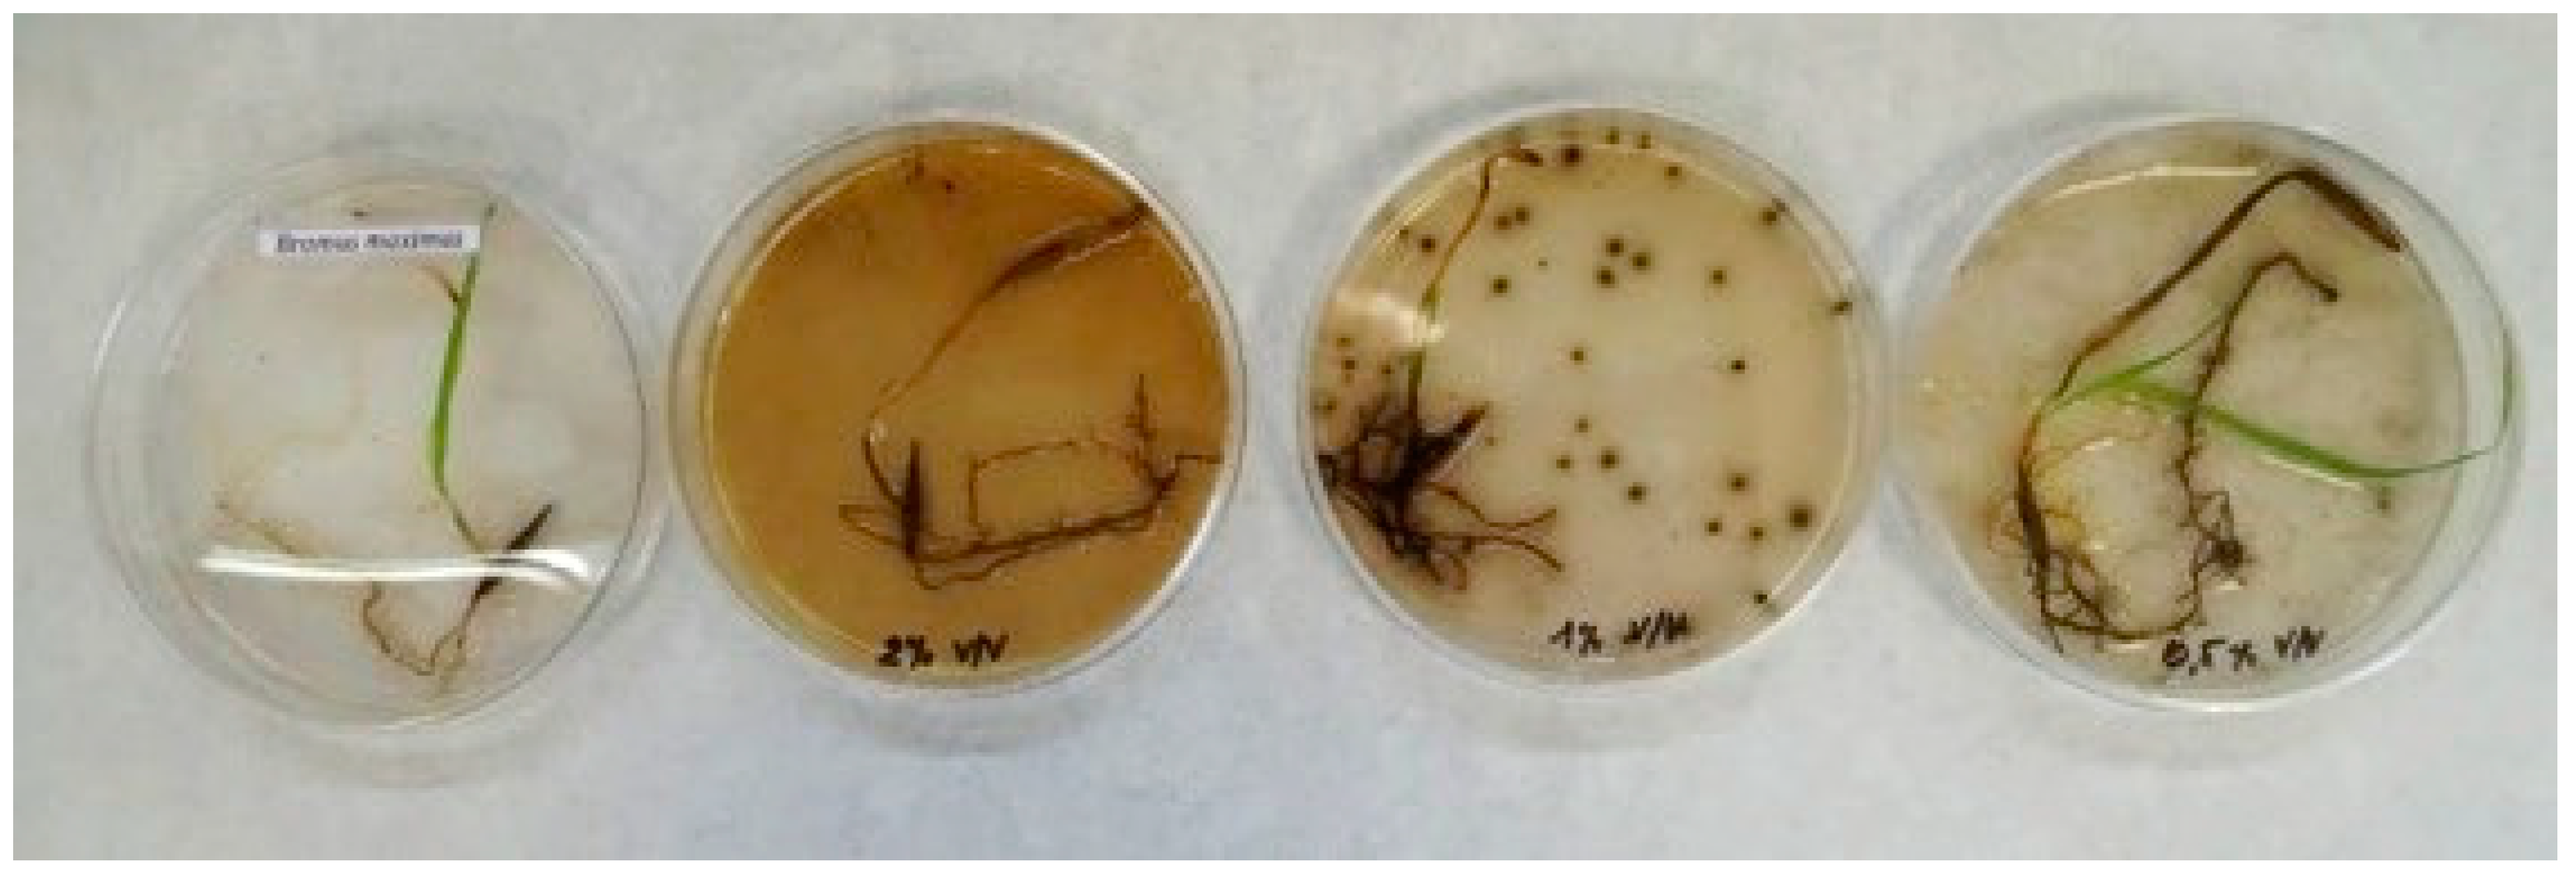
Energies 13 02418 g004

3.1. Characterisation of Wood Vinegar
The samples analysed were the wood vinegar samples obtained through continuous fast pyrolysis at the Universidad de Alcalá, and the wood vinegar used as a herbicide supplied by Neoliquid Advanced Biofuels and Biochemicals S.L. Moisture contents were 70.66 ± 7.87 wt. % for wood vinegar samples obtained in the laboratory prototype and 89.60% for the industrial wood vinegar herbicide. Moisture values reported in the literature range from 72.4 wt. % for pyroligneous acid derived from pine and forest waste [
53] to 81.44–93.48% obtained by Theapparat et al. for bamboo and nimtree, respectively [
54].
pH values were 2.04 to 2.50 (2.23 ± 0.21) for the prototype samples and 2.62 for the industrial herbicide. Reported values have been 1.8–2.9 for wood vinegar from birch [
20] and 2.2–2.4 for wood vinegar from forest waste and pine [
53].
Gas chromatography results revealed scarce composition differences between wood vinegar samples. Although derived from different biomass feedstock (poplar, pine and woody species pruning litter), they all behaved similarly during the pyrolysis process. Cellulose degradation mainly gives rise to hydroxyacetaldehyde and other carboxylic compounds such as acids and ketones through fragmentation reactions, while levoglucosan and primary sugars form via depolymerisation reactions. In turn, hemicellulose decomposes in a similar way to generate volatile organic compounds, levoglucosan and other anhydrohexoses and furans [
55,
56]. Consequently, wood vinegar contains water-soluble compounds such as polyols, carboxylic acids and phenols, derived from the decomposition of cellulose and hemicellulose. The chromatogram obtained for the sample Poplar 1 is provided in
Figure 1.
The main compounds detected in the different samples of wood vinegar including the wood vinegar herbicide used in subsequent experiments assessing its herbicidal behaviour are shown in
Table 3.
Proportions of compounds identified in the different wood vinegar samples were: 95.69% Poplar 1, 95.19% Poplar 2, 85.04% Pine 1, 87.27% Pine 2, 100% Forest pine, 98.36% Pruning litter and 94.75 WV herbicide. Remaining amounts up to 100% were coelutions and/or compounds identified with reverse match factor (RMF) probabilities lower than 700.
Regardless of the biomass feedstock, the main compounds present in all wood vinegar samples analysed were acetic acid, hydroxyacetone and hydroxyacetaldehyde. The presence of phenols, and their greater percentage areas in the samples obtained from poplar should also be mentioned. Fang et al. examined the fractionation of pyroligneous acid obtained from forest litter and pine. GC-MS analysis revealed relative contents of acetic acid and hydroxyacetone expressed as peak areas of 21.21% and 5.75%, respectively [
53]. To complete the analysis of the wood vinegar samples, major components were quantified as percentage weights using the corresponding standard (
Table 4).
The relative area of the peaks detected by GC/MS allows a quick estimation of the contribution of each compound in the composition of the samples, but it is not a quantitative parameter. For this reason and considering the peaks with the greater area observed, the majority compounds were quantified. No significant differences were detected between the samples obtained from different biomass feeds. Acetic acid concentrations ranged from 2.87 to 4.30 wt. %. Seo et al. reported an acetic acid concentration of 3.52 wt. % and 3.33 wt. % for wood vinegar derived from
Quercus sp. and rice husk respectively [
57]. For wood vinegar produced from tropical waste biomass, the concentration of this acid ranges between 32.49 and 70.60 mg/mL for eucalyptus
E. camaldulensis and
Hebea brasiliensis, respectively [
54].
Percentage weights were 1.13–2.14 wt. % for hydroxyacetone and 0.70–3.47 wt. % for hydroxyacetaldehyde. Furfural and levoglucosan concentrations were generally below 1 wt. %: 0.08 to 0.31 wt. % and 0.08 to 1.05 wt. %, respectively. The concentration of acetic acid in the industrial wood vinegar herbicide was 2.87 wt. % and its moisture content was 89.60 wt. %, determining that this carboxylic acid accounts for 27.60% in weight of the organic compounds present in the wood vinegar. Although most composition studies work with relative area on the chromatogram [
22,
58,
59,
60], this is not an exact measure of the amount of compound present in the sample. Quantification of the components is necessary to determine the exact quantity of each compound [
61,
62].
3.4. Seedling Tests
The objective of these tests was to assess the herbicidal effects of wood vinegar diluted in water on the early development of seedlings and establish the minimum concentration of this effect.
Table 6 shows the treatments used on each species and results obtained 2 and 15 days after treatment.
In experiment 1, observations 48 h after treatment with the herbicide revealed 100% mortality in response to all three dilutions tested. As an example,
Figure 3 shows the appearance of the
Silibum marianum seedlings 48 h after treatment with the wood vinegar.
In view of these findings, in a second experiment, lower concentrations of the herbicide (1.0 and 0.5 vol. %) were tested along with the 2.0 vol. % dilution. Observations 48 h and 15 days after treatment are shown in
Table 7.
Unlike the previous observations, in Experiment 2, treated seedlings remained alive 48 h after treatment and those subjected to 1.0 vol. % wood vinegar were in worse conditions than those that received the 0.5 vol. % solution of the herbicide.
Fifteen days after treatment, all the plantlets treated with 1.0 vol. % wood vinegar had died while those treated with the 0.5 vol. % dilution were still in relatively good condition (
Figure 4). These results are statistically significant, chi-square
p ≤ 0.001, between 0.5 vol. % and the other treatments.
These results indicate the good behaviour of low concentrations of the wood vinegar product in inhibiting early stages of seedling growth. Wood vinegar dilutions of 10, 5 and 2 vol. % induced the death of the seedlings within 48 h. The 1 vol. % solution led to slower plant death. According to these observations, it seems that wood vinegar has herbicidal actions when directly applied to the soil and that low concentrations may help control the development of weeds. Mmojieje and Hornung were also able to confirm the inhibitory effect of pyroligneous acid (10%) on seedlings of
Helianthus annuus (sunflower),
Solanum lycopersicum (tomato) and
Raphanus sativus (radish) [
63].
However, when the wood vinegar was used at a concentration of 0.5 vol. %, seedling growth was unaffected. This finding is in agreement with the results of a study by Aisyah et al., who found that a 0.5 vol. % solution of wood vinegar promoted the growth of banana plantlets [
65].
Other studies have shown that very low concentrations of the wood acid (0.002% and 0.02%) improve the growth of seedlings and shoots; this has been related to enhanced nutrient availability due to the slow release of active acid and phenol components [
64].
It should be noted that the presence of fungi on all filter papers was observed when the 1.0 vol. % wood vinegar solution was used. A possible explanation for this could be that at this low concentration, the vinegar acts as a source of carbon, promoting fungal growth while higher concentrations inhibit their growth. This issue requires further investigation.
3.5. Spray Test
After the tests on the germination and early growth stages of the seeds, the effects of spraying the herbicide directly on the plants were studied. The rationale for this experiment was to assess the product’s behaviour as a contact herbicide.
In the tests performed by Mmojieje and Hornung, no harmful effects on the plants were observed when a 10 vol. % solution of wood vinegar was sprayed on the leaves [
63]. Accordingly, we tested the use of 100% wood vinegar and three dilutions in water of this stock solution (25, 50 and 75 vol. %,
Table 8).
Tests were conducted on adult specimens of Anacyclus clavatus, Sinapis alba, Bromus madritensis, and Bromus maximus. The differences between the control and the sprays tests were significant, in all cases, p ≤ 0.01, Kruskal-Wallis test. Between treatments, the means were significantly different, between the 25 vol. % dilution and the rest (Mann-Whitney U test p ≤ 0.001 in all cases). There was no significant difference between dilutions at 50, 75 and 100 vol. %.
The differences between species were significant only between
Anacyclus clavatus and the rest (
p ≤ 0.05, Kruskal-Wallis test). There was no significant difference between
Bromus matritensis, Bromus maximus and
Sinapis alba (
Table 9).
Results at 10 days (
Table 10) indicated no significant differences for each dilution and species except in the case of
Anacyclus clavatus, where there was a difference between the treatments with 25 vol. % and 50 vol. % and the rest (Mann-Whitney U test
p ≤ 0.05).
Thus, the 25 vol. % wood vinegar treatment was effective in treating Bromus maximus, Sinapis alba and Bromus madritensis, giving rise to mortality rates exceeding 70% in all cases. In contrast, this same treatment used on Anacyclus clavatus caused the death of only 42% in the specimens treated.
Greatest efficiency was observed for the 50 vol. % treatment, which led to a mortality rate higher than 90% for Bromus maximus, Sinapis alba and Bromus madritensis. When used on Anacyclus clavatus, the mortality rate was 52.5%. However, the high value of the standard deviation in the cases of Sinapis alba and Anacyclus clavatus for the 25 vol. % concentration, indicate that at lower concentrations results are much less homogenous than when concentration above 50 vol. % are used.
The response to treatment with the 100 and 75 vol. % dilutions of wood vinegar was similar for Anacyclus clavatus, Bromus maximus, Sinapis alba and Bromus madritensis, provoking the death of all specimens.
The most interesting results were thus those arising from the direct application of the wood vinegar product on the adult plants (
Figure 5). The annual weeds selected here to test the effects of the wood vinegar belong to the main botanical families of nitrophilous communities worldwide. The 100% mortality produced by the pure wood vinegar among these weeds indicates its efficiency when undiluted. When diluted, its efficacy diminished but not markedly and depended on the plant treated. Grassland species such as
Bromus or cruciferous species such as
Sinapis showed high mortality even when treated with the 25 vol. % dilution. The Asteraceae species
Anacyclus clavatus was much more resistant. This difference could be related to the presence or absence of compounds with a protective effect against the physical actions of the product in the leaves. Mortality is likely caused by an osmotic reaction whereby severe damage is produced to cell membranes and thylakoid membranes in the leaves, as occurs with other fatty acids [
66].
A woody plant species, Acacia dealbata, which is invasive in the Mediterranean region, was also included (although without replicate trials). The effects observed on Acacia dealbata were transient for all concentrations of the product. Although, initially, there was early leaf damage and the plant lost most of its leaves, after a few weeks, it recovered and started to produce new leaves. This is of interest for its use as a herbicide as the woody nature of the main trunk of Acacia was able to avoid the drying out of the stems that transport fluids in the plant and consequently, although the plant was damaged, it was later able to recover. This means the wood vinegar product will not be effective against woody plants but may be used on most perennial crops with lignified stems. More studies with woody species are necessary to confirm these findings.
Consistent with our observations, Hagner reported that when applied as a spray, wood vinegar behaves as a non-selective or contact foliar herbicide destroying practically all above-ground plant mass [
67]. In a study examining the herbicidal capacity of wood vinegar by Kim et al., the product was also found to be effective when leaves were sprayed but not when the vinegar was applied to the soil [
68].
The majority of compounds in wood vinegar show very low concentrations, less than 1 wt. % Major components that constitute wood vinegar are used as smoke flavourings, as they impart much-appreciated organoleptic properties to smoked food and are safe to be used as animal feed additives [
19]. Although several studies have assessed the possible environmental effects of the product, more work in this area is needed. For example, Hagner found that soil organisms were more tolerant of wood vinegar than aquatic organisms [
67]. No long-term effects on soil microbes, nematodes or enchytraeids were found. This author found that initial risk assessment indicated the risks of wood vinegar (to soil and aquatic organisms) were negligible.
However, in a recent study, Goethen de Lima et al. [
69] found that wood vinegar may be toxic to
Daphnia magna (microcrustacea), while no genotoxicity was detected for
Allium cepae. Koc [
26] reported that wood vinegar used at different doses to protect plants and/or crops in wheat agro-ecosystems did not have a negative effect on microbial factors determined in the soil. Steiner et al. observed that the application of wood vinegar to Amazonian soils increased the metabolism of soil microorganisms by increasing microbial biomass, population growth and the microbe’s efficiency [
36]. Furthermore, Zhang observed that wood vinegar treatments of increasing concentrations significantly increased the quantity of bacteria in soils and led to a significant increase in the total quantity of microbes. It could be that wood vinegar more than directly affecting soil organisms has some impact on aquatic organisms [
70]. These data point to a need to determine environmental exposure limits and how to apply this bio-product to promote its safer agricultural use.